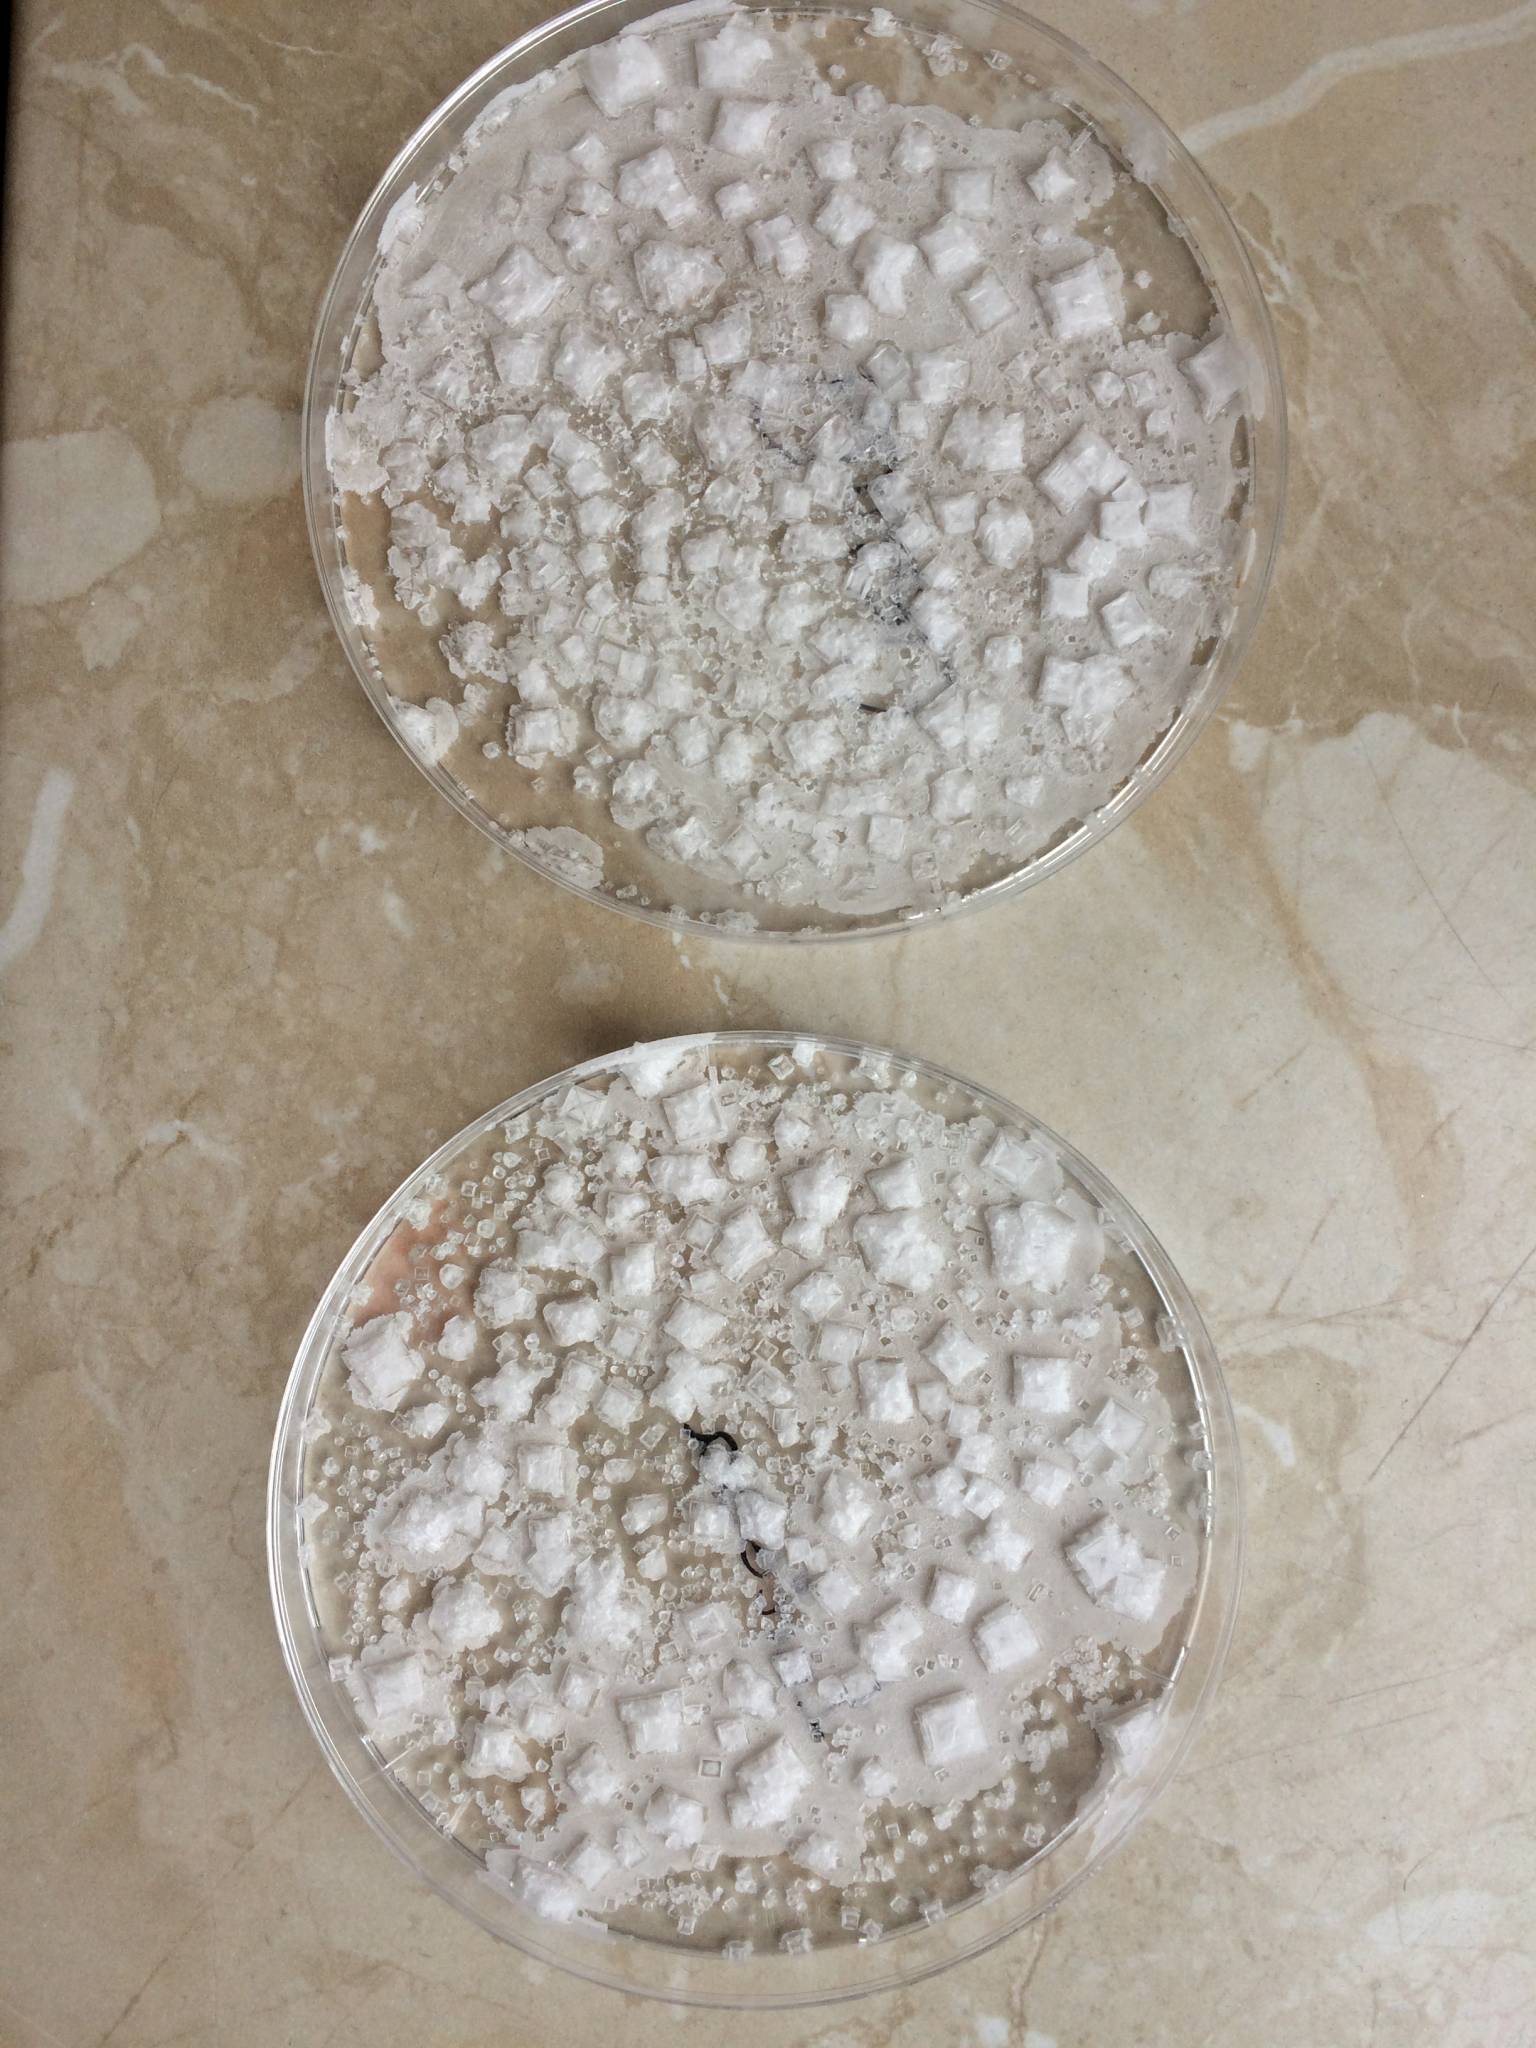

Chemie
„Chemie ist, wenn es raucht und stinkt“
Auch wenn es nicht auf jedes Experiment zutrifft, so versuchen wir im Chemieunterricht diesem Spruch immer wieder gerecht zu werden.
Auch unsere Schülerinnen dürfen im Chemieunterricht selbst Experimente machen, hierfür wurden spezielle Experimentierkästen erstellt. Mit deren Hilfe können unsere Schülerinnen beispielsweise selbst Stoffe voneinander trennen und nachweisen, Kristalle züchten, die alkoholische Gärung durchführen (Probieren darf man natürlich nicht!) oder ein Ananas-Aroma herstellen.
Experimente sind also ein wichtiger Bestandteil unseres Chemieunterrichts. Manchmal auch zum Leidwesen der Schülerinnen, denn nicht selten weht ein seltsamer Duft durch den Chemietrakt - oder wie die ein oder andere Schülerinnen sagen würden: „Hier stinkt´s“.
Kleine Salzkristalle kannst du auch ganz schnell und einfach selbst herstellen:
- Nehme ein wenig warmes Wasser und schütte etwas Salz hinzu bis es sich komplett aufgelöst hat. Dabei musst du gut umrühren!
- Du schüttest so lange kleine Mengen an Salz hinein, bis sich Salz am Boden absetzt und sich nichts mehr löst. Chemiker nennen das eine „gesättigte Lösung“.
- Nun nimmst du eine Schale und schüttest so viel von der Salzlösung hinein, bis der Boden gerade so bedeckt ist.
- Stelle die Schale an einen warmen, sonnigen Platz und warte 1-2 Tage.